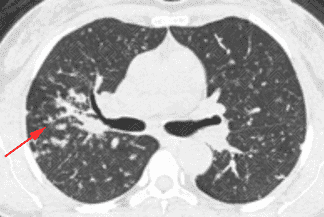
Texto alternativo para a imagem

Sarcoidose

Figuras 1, 2, 3, 4 e 5. Créditos:
Dra. Elazir Mota - Rio de Janeiro/RJ
Figuras 1, 2, 3, 4 e 5. Créditos:
Dra. Elazir Mota - Rio de Janeiro/RJ
Descrição das figuras 1, 2, 3, 4 e 5: Tomografia computadorizada do tórax com cortes axiais evidenciando pequenos nódulos distribuídos principalmente ao longo dos brônquios e vasos pulmonares (setas vermelhas). Nos cortes coronal e sagital observa-se o predomínio das anormalidades descritas nas regiões superiores e médias, de localização mais central.
Sarcoidose: Trata-se de uma doença granulomatosa sistêmica, com sua etiologia desconhecida. Caracteriza-se pela presença de granulomas epitelioides não caseosos nos órgãos envolvidos. Afeta principalmente os pulmões, linfonodos hilares e mediastinais, a pele e os olhos. Pode envolver ainda o sistema nervoso central, fígado, baço coração, músculos e ossos.
Quadro clínico : O diagnóstico demora a ser realizado, pois em boa parte dos casos, os pacientes são assintomáticos. Podem surgir sintomas respiratórios pouco específicos, como tosse, dispneia e dor torácica. Aproximadamente, 10-30% dos pacientes possuem queixas oftalmológicas, lesões cutâneas e linfonodomegalias.
-
Achados de imagem:
Os principais exames solicitados para avaliação do quadro pulmonar na sarcoidose são radiografia e tomografia computadorizada.
-
Radiografia de tórax:
- Linfonodomegalias hilares e mediastinais em geral, são tipicamente bilaterais e simétricas. As calcificações podem ocorrer em cerca de 20% dos casos;
- Alterações pulmonares: opacidades reticulonodulares e nodulares (os achados tipicamente predominam nas regiões peribroncovasculares). Nas fases mais avançadas podem surgir sinais de fibrose pulmonar;
- Importante ressaltar que estes achados podem ser de difícil caracterização na radiografia.
-
Tomografia computadorizada do tórax:
- As alterações pulmonares predominam nas regiões centrais e lobos superiores, sendo geralmente bilaterais e simétricas. Predominam os pequenos nódulos sólidos com distribuição perilinfática, ou seja, ao longo dos brônquios, septos interlobulares, vasos pulmonares e regiões subpleurais. Lesões nodulares escavadas e derrame pleural são raros na doença;
- Linfonodomegalias são observadas em cerca de 90% dos pacientes (podem inclusive ser o único achado de imagem pulmonar).
Diagnósticos diferenciais:
T
uberculose
, silicose
, reação a drogas e outras (particularmente quando pensamos no padrão de acometimento pulmonar).
Autoria principal: Elazir Mota (Radiologia, especialista em Radiologia Pediátrica).
Ganeshan D, Menias CO, Lubner MG, et al. Sarcoidosis from Head to Toe: What the Radiologist Needs to Know. Radiographics. 2018; 38(4):1180-1200.
Guidry C, Fricke RG, Ram R, et al. Imaging of sarcoidosis: a contemporary review. Radiol Clin North Am. 2016; 54(3):519–534.
Nunes H, Brillet PY, Valeyre D, et al. Imaging in sarcoidosis. Semin Respir Crit Care Med. 2007; 28(1):102–120.
Webb WR, Müller NL, Naidich DP. Doenças caracterizadas principalmente por opacidades nodulares e reticulonodulares. In: Webb WR, Müller NL, Naidich DP. TC de alta resolução do pulmão. 3a ed. Rio de Janeiro: Guanabara Koogan, 2002; 245-336.
Swensen SJ, Viggiano RW, Midthun DE, et al. Lung nodule enhancement at CT: multicenter study. Radiology. 2000; 214:73-80.